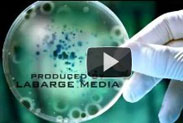

VIDEO

VIERASTA TULTA
John MacArthur
Suomentanut: Matti Leisola
UPEA VIDEO Fibonaccin lukujonosta luonnossa.

LUONTOA NUMEROINA
"Mitä enemmän opimme elämästä sitä selvemmin paljastuu kaiken suunnitelmallisuus" full screen
Programming of life
Uusinta uutta: ELÄMÄ EI OLE VOINUT SYNTYÄ SATTUMALTA

Jeesus - Jumalan viimeinen Sana
Tämä kirja, joka on koottu nauhoitetuista puheista, ilmestyi Pastori Wilhelm Buschin kuoleman jälkeen. Hän oli yksi Saksan tunnetuimmista ja suosituimmista evankelistoista.
Hänen suora ja henkilökohtainen tapansa saarnata houkutteli tuhansia ihmisiä kuuntelemaan. Busch tiesi,
että evankeliumi on kaikkien aikojen merkittävin sanoma. Siksi hän julisti sitä intohimoisesti. Hän antaa
vakuuttavasti raamatulliset vastaukset ihmisen olennaisiin kysymyksiin – kaikille ymmärrettävällä tavalla.
Kirjan kautta Wilhelm Busch jatkaa todistamista Jeesuksesta, joka kuoli ja nousi ylös meidän puolestamme.
Vuoteen 2004 mennessä kirjaa oli myyty yli 2 miljoonaa kappaletta. Se on käännetty ainakin 36 kielelle – nyt myös suomeksi.












